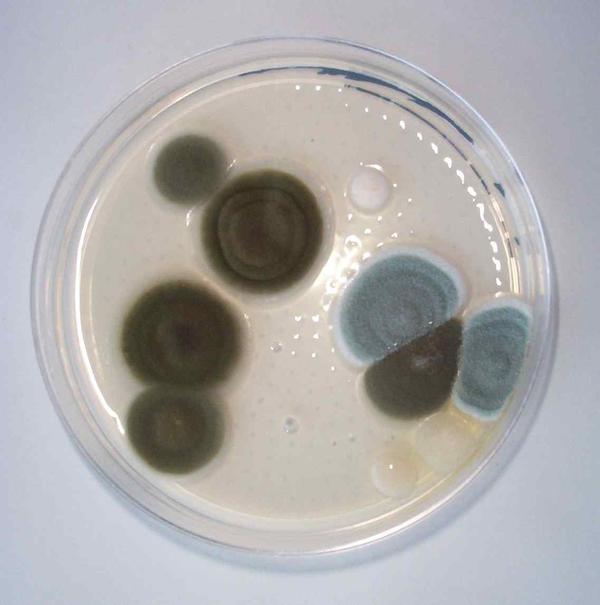

На ЧАЕС в реакторі знайшли грибок, який може стати ліками проти опромінення.
У ядерному реакторі Чорнобильської АЕС виявили грибок, який спокійно витримує найпотужнішу радіацію. Вчені пропонують використовувати його як інгредієнт для ліків проти радіації. Штам грибків, які ростуть в чорнобильському атомному реакторі, допоможе людям захищатися від небезпечних променів.
Про це пише журнал Scientific American.
Чим особливий грибок?
У 1991 році через 5 років після катастрофи в реакторі Чорнобильської АЕС на стінках знайшли чорний грибок, насичений гамма-променями. Вчені були вражені знахідкою, вони спробували з’ясувати, як цей організм вижив.
Виявилося, що він не тільки не боїться радіації, але навіть харчується нею. А все внаслідок величезної кількості меланіну – пігменту, який робить нашу шкіру коричневої від засмаги. Саме він дозволив грибку нормально поглинати шкідливі промені і потім конвертувати їх в хімічну енергію.
Вчені були вражені знахідкою, вони спробували з’ясувати, як цей організм вижив. Виявилося, що він не тільки не боїться радіації, але навіть харчується нею.
А все внаслідок величезної кількості меланіну – пігменту, який робить нашу шкіру коричневої від засмаги. Саме він дозволив грибку нормально поглинати шкідливі промені і потім конвертувати їх в хімічну енергію.
Наприклад, це допоможе онкохворим пацієнтам під час опромінення, операторам АЕС і пілотам літаків не боятися радіоактивних променів. Джерело
Друзі, Вам подобається ця стаття?
Поділіться з друзями!







